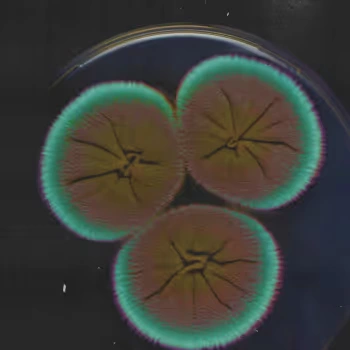
Microbiome Diversity Score

Evvy Vaginal Microbiome Test with Fertility Insights
Test for 700+ bacteria/fungi and 4 fertility-related Microbiome Markers with our at-home vaginal microbiome test.
- Free 1:1 coaching call
- Custom plan of next steps
- Option for prescription treatment (if eligible)
- Chlamydia
- Gonorrhea
- Trich
- Mycoplasma genitalium
- Ureaplasma
- 11 common microbes and more
- Highly recommended if you have symptoms
- Prelim PCR results in 1-3 business days for 4 STIs and 11 common microbes (see list)
- Final vaginal microbiome results in 7-10 days
- Reports antibiotic resistance and microbial load
- All with one easy at-home swab
Note: this panel is not yet available in NY
Advanced 3-in-1 microbiome support for gut, urinary, and vaginal health
How can Evvy support your fertility journey?
Test for four Microbiome Markers associated with fertility
Research associates a healthy vaginal microbiome with improved fertility outcomes—including higher rates of implantation and improved outcomes in IVF and IUI.
Evvy’s platform provides comprehensive testing and treatment programs to optimize your vaginal microbiome.

Protective Score
Your percent of protective bacteria
Microbiome Diversity Score
How many different kinds of bacteria you have

Fertility Disruptors
Potential pathogens identified in fertility research

STI Status
*Only included with Expanded PCR Panel add-on
Innovative & Integrative Care
01 → Science-backed results + plan
All results comes with insights into into fertility, symptoms, menopause, and more, plus a clear plan.
02 → Free 1:1 session with an expert health coach
Get an empathetic walkthrough of your results and get any questions answered.
03 → Access to precision Rx treatments
If eligible, a provider will design a custom prescription (Rx) treatment program to optimize your vaginal microbiome.
*The cost of Rx is unique to your treatment program and not included in the price of the test.

Bringing the latest fertility and vaginal microbiome research to you
Testing your vaginal microbiome with Evvy is convenient & comprehensive.
Get a test delivered straight to you in discreet packaging.
Activate your test and fill out your health forms.
Take your swab sample and send it back to our lab.
Get physician-reviewed results and a custom plan of clear next steps.
Connect 1:1 with a health coach and opt in to clinical care and Rx treatment*.
*if eligible. Note: cost of Rx treatment is not included in the test price.
700+ Microbes, One Test
Our Fertility Insights are just the beginning—we test for hundreds of disruptive and protective microbes that research has shown are related to...

- Aerobic Vaginitis (AV)e.g. E.coli, Group B streptococci
- Bacterial Vaginosis (BV)e.g. Gardnerella vaginalis, Atopobium vaginae, Prevotella bivia
- Cytolytic Vaginosis (CV)e.g. Lactobacillus crispatus
- Fertilitye.g. Microbiome Diversity Score, Fertility Disruptors
- STIs*Chlamydia, gonorrhea, trich, Mycoplasma genitalium. *Only with our Expanded PCR Panel.
- Good Healthe.g. Lactobacillus crispatus, Lactobacillus gasseri
- Recurrent UTIse.g. E. coli, Staphylococcus, Aerococcus
- Yeast Infectionse.g. Candida albicans, Candida glabrata
- Mycoplasma / Ureaplasmae.g. Mycoplasma hominis, Ureaplasma parvum, Ureaplasma urealyticum
If you’re interested, we have a longer list of what we test for here.
Get STI testing and more with our Expanded PCR Panel
Test only
PCR Panel
(mNGS)
and fungi
and fungi + STIs
FAQs
Is it safe to take an Evvy test if I’m trying to conceive or might already be pregnant?
If my fertility Microbiome Markers are suboptimal, what are the next steps?
Can I pay for Evvy with my HSA or FSA?
Is prescription treatment included in the price of the Evvy test?
Does Evvy ship internationally?
What if my vaginal microbiome is healthy and I still have difficulty conceiving?
How do Evvy’s Fertility Insights compare to traditional fertility tests at a doctor’s office?
Is Evvy peer-reviewed and CLIA/CAP/CLEP validated?
When is the right time to take a Evvy test within my fertility journey?
How often should I expect to retest my biome?
What are the age restrictions on Evvy?
How long does it take to get results?
What is Evvy's return / refund policy?














